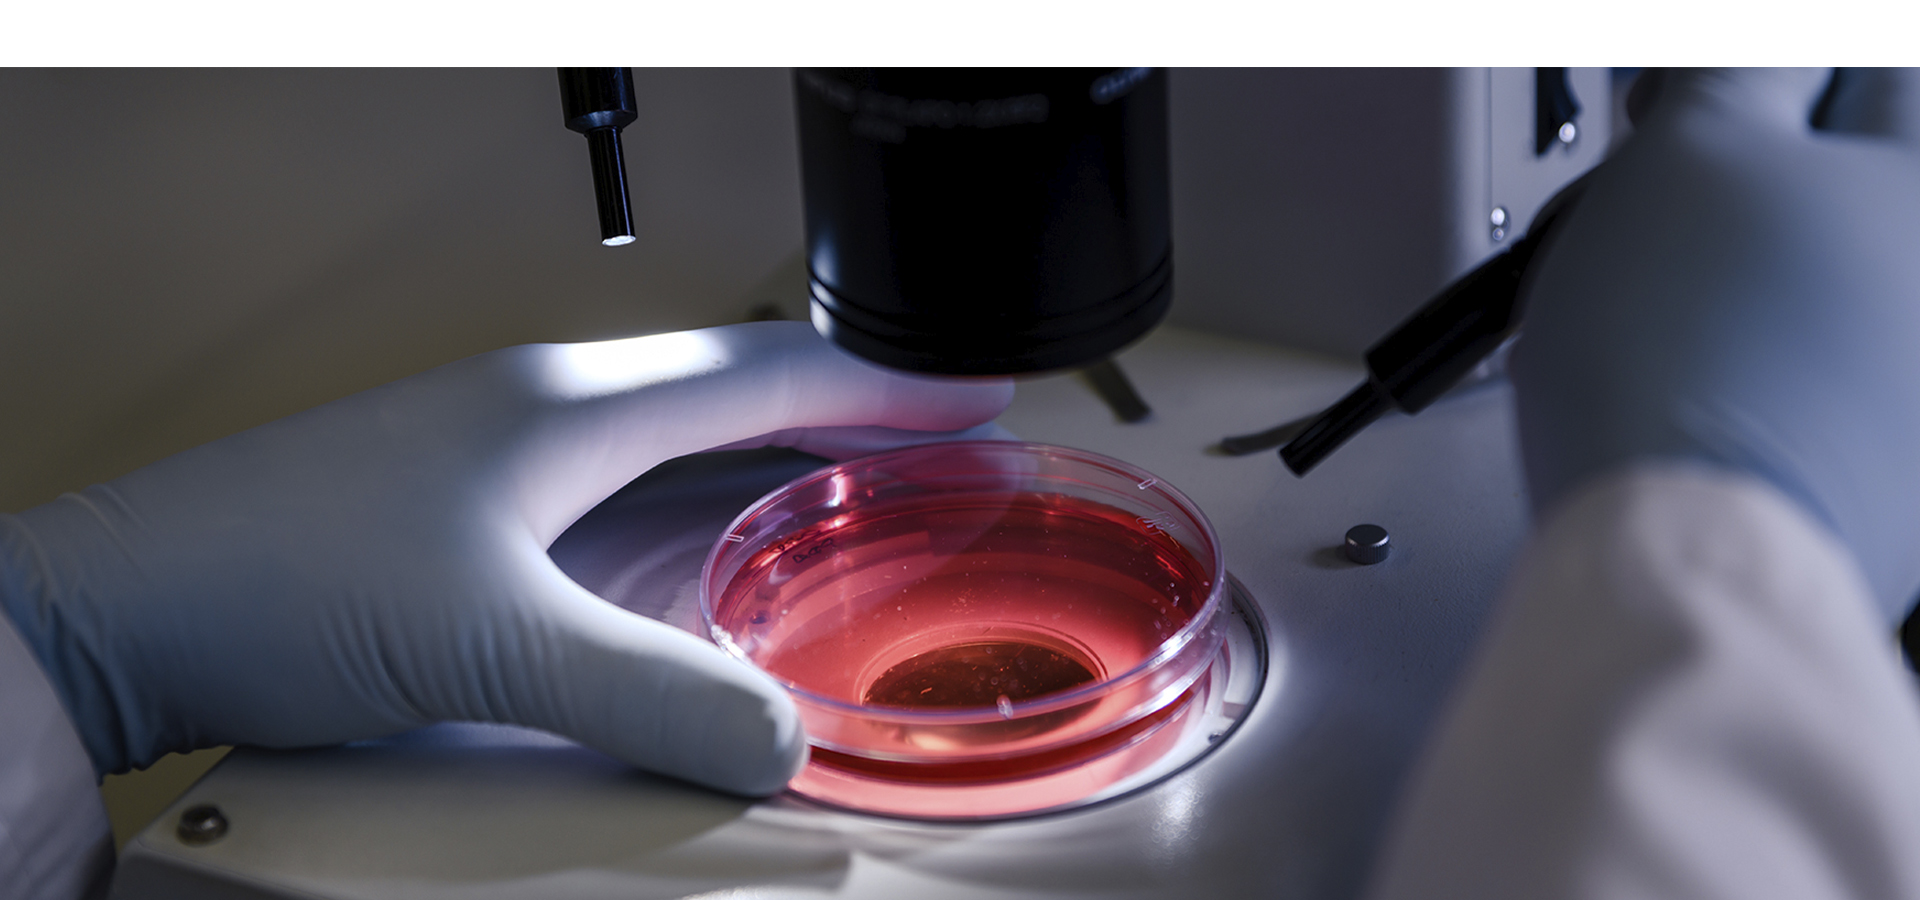
Slideshow image

Κάθε εξέταση πραγματοποιείται με επιστημονική ακρίβεια και αυστηρά ποιοτικά πρωτόκολλα.
Δίνουμε έμφαση στον σεβασμό, την εχεμύθεια και τη σωστή ενημέρωση κάθε ασθενούς.
Χρησιμοποιούμε τεχνολογία αιχμής για γρήγορα και έγκυρα διαγνωστικά αποτελέσματα.
Λειτουργούμε με επαγγελματισμό και συνέπεια, έχοντας ως προτεραιότητα την υγεία σας.
Προσφέρουμε πλήρεις αιματολογικές εξετάσεις για τη διάγνωση και την παρακολούθηση διαταραχών του αίματος, όπως αναιμία, λοιμώξεις, αιματολογικές παθήσεις και αυτοάνοσα νοσήματα.
ΠΕΡΙΣΣΟΤΕΡΑ
Οι βιοχημικές εξετάσεις συμβάλλουν στον έλεγχο της λειτουργίας ζωτικών οργάνων, όπως το ήπαρ, οι νεφροί και το πάγκρεας, καθώς και στην εκτίμηση των μεταβολικών λειτουργιών του οργανισμού.
Διαθέτουμε πλήρεις ανοσολογικές εξετάσεις για τη διάγνωση λοιμώξεων, αυτοάνοσων νοσημάτων και αλλεργιών.
Εξειδικευμένες εξετάσεις για τη διάγνωση και την παρακολούθηση ορμονικών διαταραχών, όπως θυρεοειδοπάθειες, διαταραχές αναπαραγωγής και ενδοκρινικές παθήσεις.
Διαθέτουμε σύγχρονες μεθόδους καλλιέργειας και ανίχνευσης μικροοργανισμών, για τη διάγνωση λοιμώξεων σε δείγματα αίματος, ούρων, κοπράνων και άλλων βιολογικών υγρών.
Στο ιατρείο πραγματοποιούνται εξειδικευμένες εξετάσεις για τη διερεύνηση υπογονιμότητας σε άνδρες και γυναίκες.
Προηγμένες μοριακές εξετάσεις για τη διάγνωση γενετικών και λοιμωδών νοσημάτων.
Επισκεφθείτε το μικροβιολογικό μας εργαστήριο στην Καρδίτσα και εξασφαλίστε αξιόπιστες και έγκαιρες διαγνωστικές εξετάσεις με ακρίβεια και επαγγελματισμό
ΠΕΡΙΣΣΟΤΕΡΑ